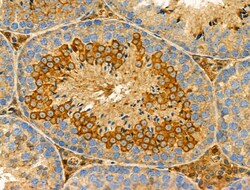
Invitrogen GSTM2 Polyclonal Antibody 100 &mu;L; Unconjugated:Antibodies,

missing translation for 'onlineSavingsMsg'
Learn More
Learn More
Invitrogen™ GSTM2 Polyclonal Antibody


Rabbit Polyclonal Antibody
Brand: Invitrogen™ PA5102386
This item is not returnable.
View return policy
Description
Antibody detects endogenous levels of total GSTM2.
At present, eight distinct classes of the soluble cytoplasmic mammalian glutathione S-transferases have been identified: alpha, kappa, mu, omega, pi, sigma, theta and zeta. GSTM2 is a glutathione S-transferase that belongs to the mu class. The mu class of enzymes functions in the detoxification of electrophilic compounds, including carcinogens, therapeutic drugs, environmental toxins and products of oxidative stress, by conjugation with glutathione.Cytosolic and membrane-bound forms of glutathione S-transferase are encoded by two distinct supergene families. At present, eight distinct classes of the soluble cytoplasmic mammalian glutathione S-transferases have been identified: alpha, kappa, mu, omega, pi, sigma, theta and zeta. This gene encodes a glutathione S-transferase that belongs to the mu class. The mu class of enzymes functions in the detoxification of electrophilic compounds, including carcinogens, therapeutic drugs, environmental toxins and products of oxidative stress, by conjugation with glutathione. The genes encoding the mu class of enzymes are organized in a gene cluster on chromosome 1p13.3 and are known to be highly polymorphic. These genetic variations can change an individual's susceptibility to carcinogens and toxins as well as affect the toxicity and efficacy of certain drugs.
Specifications
| GSTM2 | |
| Polyclonal | |
| Unconjugated | |
| GSTM2 | |
| glutathione S-alkyltransferase M2; glutathione S-aralkyltransferase M2; glutathione S-aryltransferase M2; glutathione S-transferase 4; glutathione S-transferase M1; glutathione S-transferase M2; glutathione S-transferase M2 (muscle); glutathione S-transferase Mu 2; glutathione S-transferase mu 2 (muscle); glutathione S-transferase pmGT2; Glutathione S-transferase Yb-2; glutathione S-transferase Yb2 subunit; glutathione S-transferase, mu 2; Glutathione-S-transferase mu type 2 (Yb2); glutathione-S-transferase, mu 2; Glutathione-S-transferase, mu type 2 (Yb2); GST 4-4; GST 5-5; GST class-mu 2; GST Yb2; GST, muscle; GST4; GSTA4; Gstb2; Gstb-2; GSTM; GSTM2; GSTM2-2; GTHMUS; MGC117303; S-(hydroxyalkyl)glutathione lyase M2 | |
| Rabbit | |
| Affinity chromatography | |
| RUO | |
| 14863, 24424, 2946 | |
| -20°C | |
| Liquid |
| Immunohistochemistry (Paraffin), Western Blot | |
| 1 mg/mL | |
| PBS with 50% glycerol and 0.02% sodium azide; pH 7.4 | |
| P08010, P15626, P28161 | |
| GSTM2 | |
| A synthesized peptide derived from human GSTM2(Accession P28161), corresponding to amino acid residues I194-K218. | |
| 100 μL | |
| Primary | |
| Human, Mouse, Rat | |
| Antibody | |
| IgG |
Product Content Correction
Your input is important to us. Please complete this form to provide feedback related to the content on this product.
Product Title
Spot an opportunity for improvement?Share a Content Correction